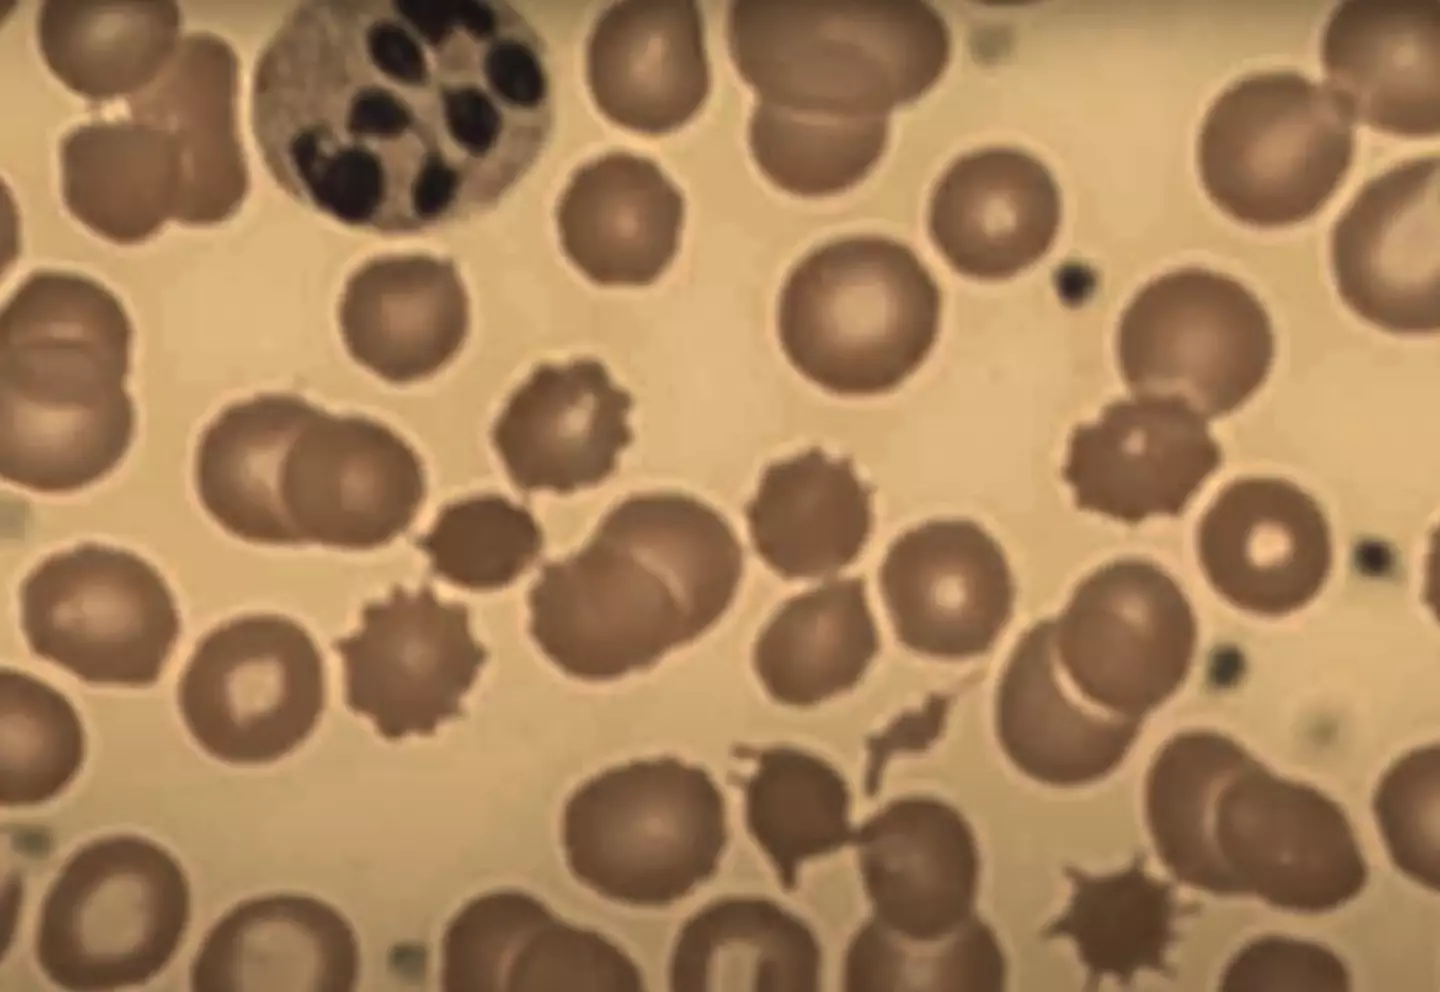

If you ever have to question whether or not your food is a bit dodgy, then you probably shouldn't be eating it.
One woman who learned this the hard way ended up developing psychosis and insomnia after chowing down on leftover sushi for dinner.
Dr Bernard Hsu, who goes by the name Chubbyemu on YouTube, shared the gory details of this unusual case on his channel.
In the clip, he explains that the 34-year-old woman, identified only as 'JC', decided to risk eating the sushi after getting home late from work and realising that everything was closed.
How, did it make her sick you maybe asking? Well, the sushi in question was five days old, which is worrying enough as it is. But what made this situation even worse is it came from a gas station.
Advert
Ironically, she was worried that she wouldn't be able to sleep if she didn't eat before bed - not realising that her late-night snack would result in countless sleepless nights in the months to come.
JC ignored the warning signs, deciding to mask the 'sour' taste with soy sauce, and four months later, the problems started.
Around this time, she developed insomnia and would toss and turn in bed until the sun rose each morning.
It got to the point where she would dread going to sleep, and the issues creeped into the daytime too.
At times, she felt her heart beating in her neck and she began suffering from stomach cramps.
Advert
"Sometimes it'd be followed by the loosest and most watery stool she's ever had in her life," said Dr Hsu.
"She told her husband that it felt like a fish was flapping around in her belly."

Eventually, JC started to hallucinate and she would see bugs crawling on her wall or underneath her skin.
One night, her hands and feet went numb. As she got out of bed, she urinated on herself, and JC and her husband decided to go to the hospital.
Advert
Initially, doctors couldn't see anything wrong with her and recommended that she try cognitive behaviour therapy for her insomnia.
As expected, this didn't work, and her health continued to spiral until she had a seizure.
After their second hospital visit, medics put her blood under a microscope and discovered that she had larger and less red blood cells than normal, but they were also not maturing fully.
Her white blood cells were also found to be malformed, according to the video from 2020.
Another exam found that JC had something called sensory ataxia, a disorder that interrupts sensory feedback signals and would explain why she'd been unable to control her bladder and experiencing hallucinations.
Advert
Doctors suggested that the reason for both issues could be caused by 'potential malnourishment'.
Dr Hsu explained: "Her husband confirms that over the last several months, she decreased her daily intake from two meals down to just breakfast in the morning."
Additional tests discovered that JC had worryingly low levels of the vital vitamin B12, which can lead to neurodegeneration.
With this in mind, doctors gave her a B12 shot and some supplements to take at home and for a while, it seemed to do the trick - her sleep returned, she was eating more and the psychosis stopped.
Advert
But two months later, the symptoms returned.
After having another seizure, JC once again found herself in the emergency room.
Following more blood tests, doctors discovered all of the same problems as before, despite the fact that she had been taking the supplements and eating more.
At this point, medics took a different route and decided to examine JC's stool - and this is when everything started to make sense.
"They found eggs measuring 40 by 60 micrometres long," said Dr Hsu. "It wasn't just a couple of eggs - there were thousands.
"This was in addition to segments that probably broke off of what appeared to be a species of tapeworm."
Asking JC if she'd eaten any grains or fish, she suddenly remembered the gas station sushi.
It turns out that tapeworms have a particular appetite for B12, meaning they'd been sucking it out from JC's supply this whole time.
It also explains why she felt better after the shot, as the B12 went straight to her bloodstream before reaching the parasites.

"Her nerves started wasting away because the wrong chemicals were made in the cells without vitamin B12," added Dr Hsu.
"Even though tapeworm can lay over one million eggs per day and live 10 years in the human gut, all it takes is a single dose of parasitic medicine to cure JC."
Following a nine-month ordeal, just one dose of medicine meant JC was finally able to get a good night's rest.
No doubt that was the last time she tried eating five-day-old food - especially from a gas station.
Topics: Food And Drink, Health, Weird